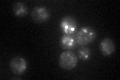
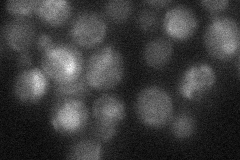

View description
Ferrioxamine B transporter, member of the ARN family of transporters that specifically recognize siderophore-iron chelates; transcription is induced during iron deprivation and diauxic shift; potentially phosphorylated by Cdc28p
Localization:
Intensity:
Fold change:
Significance:
-
C’ GFP library in SD
vacuole34.79 -
N' NOP1pr-GFP in SD

vacuole39.0146 -
N' TEF2pr-mCherry in SD

cell periphery,vacuole47.8497 -
N' NATIVEpr-GFP in SD
vacuole17.4648 -
N' TEF2pr-VC and Cyto-VN in SD

#N/A0 -
C’ GFP library in SD+DTT

vacuole18.930.54Yes -
C’ GFP library in SD+H2O2

vacuole34.450.99No -
C’ GFP library in Starvation Media

vacuole22.790.65Yes -
C’ GFP library on the background of Pup2-DaMP

vacuole -
C’ GFP library on the background of CCT mutant

vacuole19.7820.568475Yes
